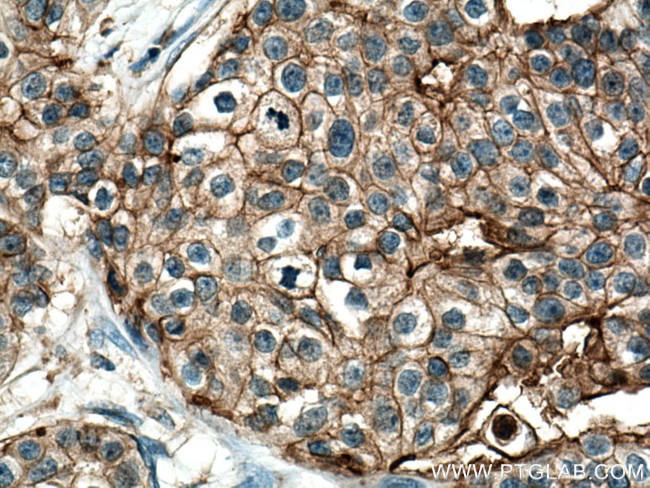
GNA13 Antibody in Immunohistochemistry (Paraffin) (IHC (P))

Search
Proteintech
GNA13 Monoclonal Antibody (2G8F10)
{{$productOrderCtrl.translations['antibody.pdp.commerceCard.promotion.promotions']}}
{{$productOrderCtrl.translations['antibody.pdp.commerceCard.promotion.viewpromo']}}
{{$productOrderCtrl.translations['antibody.pdp.commerceCard.promotion.promocode']}}: {{promo.promoCode}} {{promo.promoTitle}} {{promo.promoDescription}}. {{$productOrderCtrl.translations['antibody.pdp.commerceCard.promotion.learnmore']}}
产品信息
67188-1-IG
种属反应
宿主/亚型
分类
类型
克隆号
抗原
偶联物
形式
浓度
纯化类型
保存液
内含物
保存条件
运输条件
产品详细信息
Aliquoting is unnecessary for -20°C storage.
靶标信息
Guanine nucleotide-binding proteins (G proteins) are involved as modulators or transducers in various transmembrane signaling systems (PubMed:15240885, PubMed:16787920, PubMed:16705036, PubMed:27084452). Activates effector molecule RhoA by binding and activating RhoGEFs (ARHGEF1/p115RhoGEF, ARHGEF11/PDZ-RhoGEF and ARHGEF12/LARG) (PubMed:15240885, PubMed:12515866). GNA13-dependent Rho signaling subsequently regulates transcription factor AP-1 (activating protein-1). Promotes tumor cell invasion and metastasis by activating RhoA/ROCK signaling pathway (PubMed:16787920, PubMed:16705036, PubMed:27084452). Inhibits CDH1-mediated cell adhesion in process independent from Rho activation (PubMed:11976333). [UniProt]
仅用于科研。不用于诊断过程。未经明确授权不得转售。
篇参考文献 (0)
生物信息学
蛋白别名: G alpha 13; G alpha-13; G-protein subunit alpha-13; Galpha 13; guanine nucleotide binding protein (G protein), alpha 13; guanine nucleotide binding protein, alpha 13; Guanine nucleotide-binding protein subunit alpha-13
基因别名: AU024132; AU043124; G13; Galpha13; Gna-13; GNA13
UniProt ID: (Human) Q14344, (Mouse) P27601, (Rat) Q6Q7Y5
Entrez Gene ID: (Pig) 100522824, (Human) 10672, (Mouse) 14674, (Rat) 303634